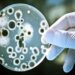
जळगाव जिल्ह्यात आढळला ‘लेप्टोस्पायरोसिस’ आजाराचा रुग्ण

सोलापूर,(प्रतिनिधी)- मोहोळजवळील यावली गावाजवळ मालट्रक व कारच्या धडकेत झालेल्या अपघातात अहमदनगर जिल्ह्यातील चार महिलांचा मृत्यू झाला असून, सहा जण जखमी झाल्याची दुर्दैवी घटना बुधवारी सकाळी ९ वाजताच्या सुमारास घडली.

रांजणगाव (ता. पारनेर, जिल्हा अहमदनगर) येथील महिला भाविक कारमधून तुळजापूरसाठी दर्शनासाठी जात होते. कारची यावली गावच्या परिसरात पुणे- सोलापूर महामार्गावर सोलापूरकडे जाणाऱ्या मालट्रकला पाठीमागून भीषण धडक बसली. तीन महिलांचा जागीच मृत्यू झाला.

चौथ्या महिलेचा सोलापूरच्या शासकीय रुग्णालयात मृत्यू झाला. अपघातामध्ये कार चालक आदमली मनावरली शेख (वय ३७), हिराबाई रामदास पवार (७५), कमलाबाई मारुती वेताळ (६०), द्वारकाबाई नागनाथ गायकवाड (४०) यांचा मृत्यू झाला.